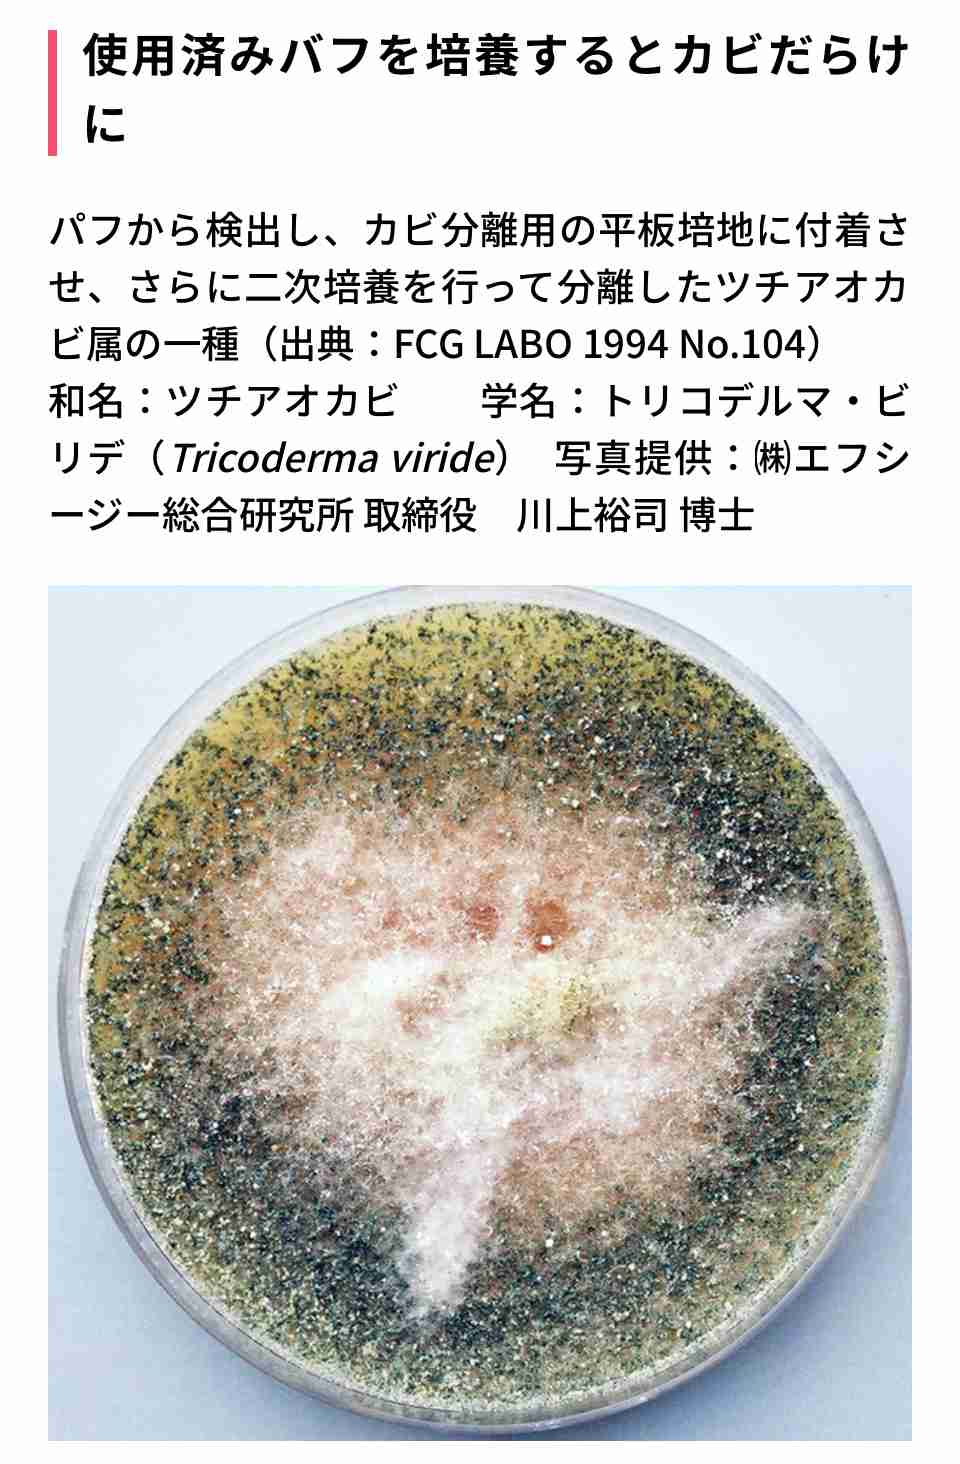
古い化粧品を使って起きたトラブル…

-
1. 匿名 2024/01/01(月) 22:36:14
ありますか?
忘年会に日頃は使わないチークにアイシャドウをつけて行きました。
そもそも安物だったのにいつの物かわからないくらい古い物です。多分10年前くらい…
その夜、目の周りがどんどん潰れていくような勢いで腫れて、頬骨辺りもぼっこり腫れて3日間お化けのような顔になりました。
その時は忘年会でお酒を飲み過ぎたのかな?とか食べ合わせが悪かったのかな?と思いましたが、今となればおそらく古い化粧品が原因だったのでは?と思っています。
みなさんは何かありますか?+268
-71
-
2. 匿名 2024/01/01(月) 22:36:53
汚ねぇ+67
-87
-
3. 匿名 2024/01/01(月) 22:37:22
20年前の目薬使って失明した+7
-213
-
4. 匿名 2024/01/01(月) 22:37:24
賞味期限
消費期限
と同じように使用期限ってものがある
化粧品にも明記してほしい+773
-10
-
5. 匿名 2024/01/01(月) 22:37:28
>>1
うーん、もともとがどのくらいの安物だったのかわからないけど、ドラッグストアで買ったレブロンのチークは10年くらい経つけどなんともないですよ。
+457
-36
-
6. 匿名 2024/01/01(月) 22:37:29
ハンドクリームも3年ていうしな+90
-4
-
7. 匿名 2024/01/01(月) 22:37:50
顔につける物だから10年前は怖くてつけられない+398
-10
-
8. 匿名 2024/01/01(月) 22:38:09
>>3
それなのにガルちゃん出来るの!?+153
-4
-
9. 匿名 2024/01/01(月) 22:38:17
ブルベ春のナチュラルボーンクラッシャー+4
-22
-
10. 匿名 2024/01/01(月) 22:38:32
>>4
開封前なら2年以内に…とか言われてるけど、それなら使用期限はっきり書いて欲しいですよね+405
-4
-
11. 匿名 2024/01/01(月) 22:38:32
肌に塗る物は怖くて使えなくなるけど
アイシャドウとかなくならないよね+305
-2
-
12. 匿名 2024/01/01(月) 22:38:34
>>3
ごしゅーしょーさまです+7
-14
-
13. 匿名 2024/01/01(月) 22:38:44
チークはまだしもアイメイクは使用期限ちゃんとしないと
目は怖いよ+196
-2
-
14. 匿名 2024/01/01(月) 22:39:08
>>4
韓国コスメだと製造日と使用期限書いてあるんだよね。日本もそうして欲しいわ。+98
-80
-
15. 匿名 2024/01/01(月) 22:39:21
ないなあ。久しぶりに使ってクサーと思いながらパウダーファンデ付けたけど、特に何もなし+17
-18
-
16. 匿名 2024/01/01(月) 22:39:31
医療職だけど、その腫れ方はアナフィラキシーとかを疑ってもいいレベルなのではと思うけど… 化粧品の可能性もあるかもだけど飲み会で食べたものとかもう一度思い出してみて。もし食べ物なら次食べた時命に関わるから。+534
-4
-
17. 匿名 2024/01/01(月) 22:40:00
>>5
けど、オーストラリアで『8年前のアイシャドウで失明した女性』っていう記事も前にガルちゃんで見たし、使うことを推奨すべき物ではないと思う。
菌が繁殖したり色々あるし、プチプラならなおさらマメに捨てたほうがいいのでは
+258
-7
-
18. 匿名 2024/01/01(月) 22:40:01
化粧品めちゃめちゃコレクションする人って大丈夫なのかね?といつも思う+272
-2
-
19. 匿名 2024/01/01(月) 22:40:10
>>10
開封前とはいえ、いつ作られたん?ってくらい売れ残ってるコスメあるから、製造年月日も書いて欲しいね+235
-1
-
20. 匿名 2024/01/01(月) 22:40:11
BBAのアドバイスなんか意味ない
バカが
+0
-56
-
21. 匿名 2024/01/01(月) 22:40:42
>>1
さすがにそんな昔の化粧品怖くて使わないよ!見つけたら捨てる+94
-2
-
22. 匿名 2024/01/01(月) 22:41:10
![古い化粧品を使って起きたトラブル…]()
+289
-2
-
23. 匿名 2024/01/01(月) 22:41:11
>>1
叔母が10年以上昔のファンデ使ってて、びっくりした。もっと古いかも?祖母が昔化粧品の店を個人でやっていて、それの在庫。メーカーはしっかりしたところのやつなんだけど、肌につけるものは怖くて私は無理です…。+154
-5
-
24. 匿名 2024/01/01(月) 22:41:12
今年の夏に買って使ってたリキッドファンデ、来年の夏また使えますか?+58
-5
-
25. 匿名 2024/01/01(月) 22:41:20
>>4
健康被害が出るから厳格に管理しなくちゃならないならコンタクトレンズ並みに法律で規制されてるはずだからチークやパウダーファンデ等の使用期限は自称美容家とか沢山売りたい企業が適当言ってるだけだと思う+240
-8
-
26. 匿名 2024/01/01(月) 22:41:30
3年ぐらい前に買った開封済みのクレドの下地を使ったら肌荒れした+17
-3
-
27. 匿名 2024/01/01(月) 22:41:42
メーカーによっては製造番号を調べたら、製造月が分るのあるけど、まどろっこしいことせんと、ズバッと製造年月日印刷してくれたら良いのに。+151
-2
-
28. 匿名 2024/01/01(月) 22:42:11
化粧道具にはなっちゃうけど、古いビューラー使ったら、おもいっっっきりほぼ根本からまつ毛切れた
マジで定期的に変えた方がいい
また生えてきたけどね+118
-10
-
29. 匿名 2024/01/01(月) 22:42:13
乾燥でまぶたの皮がめくれるんだと思っていたら、新しいアイシャドウにしたら荒れなくなったから古い化粧品のせいだったのかな。+57
-2
-
30. 匿名 2024/01/01(月) 22:42:16
ずっとしまいこんでいたサンプル品、開封してないから。と旅行に持って行ったら、ぼろぼろ湿疹出たことある。その頃サンプル品集めにちょっと凝ってて試すより集める方向になってたんだけど、それを気にたくさん捨てた。+136
-5
-
31. 匿名 2024/01/01(月) 22:42:29
>>7
眉用のパウダー20年前に買ったやつたまに使ってるけど問題なし+90
-11
-
32. 匿名 2024/01/01(月) 22:42:48
海外では10年前のアイシャドウで失明した人も居るから、長くても未開封で3年が限界だと思ってる+72
-4
-
33. 匿名 2024/01/01(月) 22:43:38
出産して体質が変わって、尋常性乾癬になったら新品でも痒くなるから、10年前の化粧品なんてあり得ない……+43
-1
-
34. 匿名 2024/01/01(月) 22:43:42
>>20
新年早々に荒ぶってるねー。+31
-3
-
35. 匿名 2024/01/01(月) 22:44:23
明確には書いてないけど、一応半年から1年くらいが目安と言われてる+17
-0
-
36. 匿名 2024/01/01(月) 22:44:49
>>30
パウチのサンプルだよね?未開封とはいえ早めに使った方がいいんだね。つい長期間使わずに取っておきがち。+102
-1
-
37. 匿名 2024/01/01(月) 22:45:10
10年ものふつうに毎日使ってる…
リップとリキッド系はなんとなく1年以内で処分してるけどパウダー系はずっと使ってる 減らん+88
-5
-
38. 匿名 2024/01/01(月) 22:45:21
>>20
此処で下らない虚勢張って、自己紹介して楽しそうだね+11
-3
-
39. 匿名 2024/01/01(月) 22:45:45
>>11
アイシャドウ10年以上前の古いの使ったら目に出来物できて眼科で3,800円処方箋薬局で1,500円くらい払った
その金額あれば良いアイシャドウ買えてたわ+205
-3
-
40. 匿名 2024/01/01(月) 22:45:53
>>15
クサイのはヤバいw雑菌繁殖してるよ+62
-1
-
41. 匿名 2024/01/01(月) 22:46:02
ロレアルパリのアイシャドウへらなくて11年前のまだ使ってるんだけどヤバいのかなw
さすがにもうそろそろ無くなりそうだから新しいの買おう…+28
-2
-
42. 匿名 2024/01/01(月) 22:46:08
>>30
やはりそうなんだ…
掃除して見つかったんだけど、2年前は捨てたけど1年前は平気かな?+6
-0
-
43. 匿名 2024/01/01(月) 22:46:53
>>1
皮膚に傷かなんかあって
チークにカビか雑菌がわいていて
傷から入り込んだのでは
そんなに腫れるって+141
-3
-
44. 匿名 2024/01/01(月) 22:48:14
>>4
書いてないやつは3年ってルールなかったっけ?+22
-0
-
45. 匿名 2024/01/01(月) 22:48:26
>>4
明記してないものは3年だよ+24
-3
-
46. 匿名 2024/01/01(月) 22:48:53
>>22
なつかし!
同じの持ってた+331
-0
-
47. 匿名 2024/01/01(月) 22:48:54
>>22
これ好きだったな…
+169
-1
-
48. 匿名 2024/01/01(月) 22:49:05
>>4
書いてあるのもあるよ
海外製(ディオールシャネルとか外資)はだいたい書いてある
なんか箱開けたみたいなイラストの中に12Mとか書いてある(開けてから12ヶ月で使い切ってねって意味、6Mなら6ヶ月以内)
ちな開封前なら特に期限はない、とは言っても3年くらいだと安心+101
-4
-
49. 匿名 2024/01/01(月) 22:49:27
いつ開けたか覚えてないずいぶん前の色付きリップクリームつけたら唇がかゆくなって赤く腫れたことある。
すぐ拭き取って捨てた…+11
-1
-
50. 匿名 2024/01/01(月) 22:49:29
>>3
てか、液体揮発しないか?+32
-1
-
51. 匿名 2024/01/01(月) 22:49:30
>>1
ファンデ。
頰を中心にめちゃくちゃ荒れた。
それからはきちっと開封日書いて気をつけてる。+30
-0
-
52. 匿名 2024/01/01(月) 22:50:18
>>22
コレはさすがにヤバそうな…+118
-0
-
53. 匿名 2024/01/01(月) 22:50:40
>>24
知り合いは1年以上前に買ったリキッドファンデ時々使ってる。本人は問題なさそうだけど...
捨てなって言っても大丈夫って言ってる。とりあえず匂い嗅いでみなって言っても空返事。もう自己責任としか言えない。+8
-22
-
54. 匿名 2024/01/01(月) 22:51:54
キャンメイクのアイシャドウ、半年ぶりに使おうと思ったらブラシがカビ生えてたよ+5
-18
-
55. 匿名 2024/01/01(月) 22:53:05
どんなに長くてもコスメは一年経ったら捨てるようにしてる
風水とか信じてないけど古いコスメ持ってると顔も古くなるとか言われたことあるから(単純に古いコスメ使ってると古いメイクになる、もしくは酸化して老ける原因になる?)
ファンデ、下地、マスカラ、リップは半年で捨てる
だからアイシャドウやチークはデパコス買えない、、
ファンデや下地は毎日使うから半年くらいでは使い切れるからいいんだけど+37
-7
-
56. 匿名 2024/01/01(月) 22:53:24
>>16
でも目の周りから腫れるならやっぱり化粧品かも
食べ物なら口や喉にまず違和感あるはず+3
-69
-
57. 匿名 2024/01/01(月) 22:55:54
>>1
私は10年以上前のを今も使ってるけどトラブルになったことはないから、主さんがたまたま体が弱ってたとかじゃないかな?そうすると肌も敏感になるから、古い化粧品にかぶれたりするよね…。+73
-6
-
58. 匿名 2024/01/01(月) 22:56:06
>>22
懐かしすぎる+134
-0
-
59. 匿名 2024/01/01(月) 22:58:32
モデルの仕事をしてた頃の話ですが、ご高齢のメイクさんが持ってきたメイク道具が古い上に汚ならしくて😭
「衛生的に不安だからやめて!」が本音だけど、波風立てたくないしどうしようってハラハラしてる内に、平たい容器に入ったリップ下地(口紅の色がいくつか混じり、埃みたいなものもついてる🤢)を塗られました。
1週間ほど唇が炎症し、ピリピリとした痛みが続きました。それからトラウマになり、メイク道具を綺麗に扱わないメイクさんにはNGを出すようになりました。雑な人は使用期限も守らないだろうから、警戒してしまいます。+128
-3
-
60. 匿名 2024/01/01(月) 22:58:37
なんか、10年たてばチークは顔色に合わなくなってアイシャドウはビミョーに流行りの色味ではないことに気付きそうだけど…そんなに長く使えるアイテムを選べていたならそれはそれですごいと思った
私もふるいの引っ張りだすことはあるけど、結局使えないなとなってセーフだっただけかも。
例えば10年前はイエベブルベなんてあんま知らなくてもろピンクのチークだったし、アイシャドウはラメラメ。今はブラウンのチークにマットアイシャドウだもん。+7
-10
-
61. 匿名 2024/01/01(月) 23:00:39
>>1
化粧品にも使用期限あるので気を付けて下さい
とにかく菌が大繁殖してた筈+31
-0
-
62. 匿名 2024/01/01(月) 23:00:59
アイシャドーで瞼晴れた経験あるよ+9
-0
-
63. 匿名 2024/01/01(月) 23:01:03
>>1
日焼け止めも入れていいですか。
1年経ったら効果なくなって日焼けした。ぬって少ししたらちょっと痒みもあったんだよね…新しいのを買ったらトラブル無し。+43
-1
-
64. 匿名 2024/01/01(月) 23:01:13
>>22
私コレのブラウン系持ってた。
全色揃えた子もいた。
よく考えたら、ブラウン系がギリギリで全部難しい色合いよね。
なのにすごい売れたなあ。
使う事考えないでコンプして捨てそびれて抽斗に眠ってる人案外いるかも+129
-3
-
65. 匿名 2024/01/01(月) 23:02:01
若いときならなんともない化粧品でも年取ったら急に体質変わってかぶれたりする。化粧品は悪くないケースもあるから一概には言えないのよね……+15
-1
-
66. 匿名 2024/01/01(月) 23:03:51
>>22
懐かしい。
何個もリピして使ってたよ。
44歳の私が19、20歳の頃に。+174
-2
-
67. 匿名 2024/01/01(月) 23:04:16
捨てな+1
-3
-
68. 匿名 2024/01/01(月) 23:05:55
>>48
6ヶ月でアイシャドウ使い切れないよ
今年中にDior使い切ろうかな、2年位になるし+55
-0
-
69. 匿名 2024/01/01(月) 23:06:07
>>17
アイシャドウとかアイライナー、マスカラ、あと口紅やグロスは流石に怖くて使えないけど、チークはなんとなく使い続けてました。
コロナでマスク生活のときにチークつかわなくなっちゃったんですよね…+41
-0
-
70. 匿名 2024/01/01(月) 23:08:17
>>22
このパケ35歳の私が高校生の時代のだから20年前とか?
アイシャドウよ色味も時代を感じるね+110
-0
-
71. 匿名 2024/01/01(月) 23:08:18
>>18
廃番になるから買いだめっていうのもよくない気がする。未開封でも劣化するよね。+97
-1
-
72. 匿名 2024/01/01(月) 23:21:10
>>16
そうだね。飲み会の食べ物もあるかもしれないし、それかそのプチプラの化粧品の成分のアレルギーかもしれないし。+134
-0
-
73. 匿名 2024/01/01(月) 23:21:38
その物もだけど 使うシャドーブラシとかチップとかもだよね!
使い捨てがいいと思う!+7
-0
-
74. 匿名 2024/01/01(月) 23:22:54
>>45
そうなんだ…気が向いたときに買い足しちゃってどれがいつのってわからなくなるから、製造日は記載して欲しいね
+8
-0
-
75. 匿名 2024/01/01(月) 23:24:17
>>1
ケースや置いてた周りにホコリとか溜まってなかった?それも付着して顔についた可能性もあるかも。
なんにせよ、10年は怖いです…+6
-2
-
76. 匿名 2024/01/01(月) 23:24:59
>>19
そうそう
ファンデーションとかは正規店で買うか、ネットでは新製品しか買いません+33
-0
-
77. 匿名 2024/01/01(月) 23:25:04
>>1
古くて雑菌が繁殖していたのかもしれないけど、
主さんカルミンアレルギーの可能性無いですか?
カルミンとは虫由来のコチニール色素で、
赤系の化粧品によく使われています。
マカロンとかいちご系の食べ物にも入っていて蓄積するとアレルギー反応でるから気をつけた方がいいかも。
+76
-0
-
78. 匿名 2024/01/01(月) 23:26:00
>>42
その人の肌の状態によるからなんとも言えないけど、手に入れたのが1年前でも、その店舗等で保管されてきた期間はわからないからやめたほうがいいよ。
最近よくあるホテルのフロントでアメニティお好きなのをどうぞ。も私はなんかイヤ。+8
-3
-
79. 匿名 2024/01/01(月) 23:26:27
>>63
日焼け止めはさすがに何年もはないけど、1シーズンで使い切れたことがなく、翌年の初めとかにちょっと塗っちゃうことはあります。。
あと、地味にボディクリームはほんとなくならない。ニベアボディみたいなそんなに高くないやつ使ってるけど、冬だけ脛に塗るくらいだし、あと寒い時にはすぐパジャマ着て靴下履いてしまうから、塗り忘れも多いから全く減らない。+34
-1
-
80. 匿名 2024/01/01(月) 23:26:32
>>1
メイクの販売員ですが、未使用品でも3年が目安になります
シャドーなどに含まれる油が酸化する為です
良質なお品でも参加します
使用していれば顔の脂や汚れ等で、どんなに綺麗に使っていても少しずつ傷みますので、お肌の弱い方は半年から1年を目安に使い切って下さいね
使い切れない場合もあると思うのですが、最近は少量入りの物もありますので+72
-6
-
81. 匿名 2024/01/01(月) 23:27:06
>>59
ずっと気になってたのですがメイク道具って使い回しですか?ブラシやチップ変えても他人の垢は付くんじゃないかなとか、メイク道具だけは自分で持っててそれを使ってもらうこともあるのかなとか…+31
-2
-
82. 匿名 2024/01/01(月) 23:27:16
>>18
全然使いきれないのにコスメ好きだからどんどん溜まっていく。プチプラは中身少ないしプラスチックのケースに入ってるだけだから捨てやすいけど、デパコスってたくさん入ってて全然無くならない上に、ケースも鏡とかついてたりデザインこだわってるから、捨てるのも分別とかよくわからなくて面倒くさくて、余計溜まっていく…
値段半分にして半分の量にするとか考えて欲しい。+112
-2
-
83. 匿名 2024/01/01(月) 23:27:26
>>56
食品のアレルギーある知人はアレルギーのある物質食べてしまって目を痒がってたよ。
私は足のスネやらウデやら全身が痒くなる+39
-1
-
84. 匿名 2024/01/01(月) 23:27:45
>>17
昔ブラマヨの吉田の私物のファンデーションを検査したら大腸菌が繁殖してたってのを見た
ブツブツを隠すためのつもりが更に肌に負担をかけて悪化させていた
古いものでも見た目にはキレイだからわからないよね+86
-0
-
85. 匿名 2024/01/01(月) 23:29:29
>>31
私も。20年結構ある
+21
-1
-
86. 匿名 2024/01/01(月) 23:39:55
>>36
そうそう
私もそれに気付いて
直ぐ使う様になった。+0
-0
-
87. 匿名 2024/01/01(月) 23:41:57
私よく口紅やグロスとか腐らせるんだけど
特に肌トラブルは起きた事ないけど
腐った口紅って全部粘土みたいな匂いになるよね+10
-1
-
88. 匿名 2024/01/01(月) 23:44:52
>>86
それこそサンプルもいつ作られたのか分からないしね
これ言い出したらキリないけど🤣+8
-0
-
89. 匿名 2024/01/01(月) 23:45:22
>>84
うんこした後手を洗わないで触ったってこと?+9
-2
-
90. 匿名 2024/01/01(月) 23:45:25
私肌弱くミネラル化粧品しか使わないから余計に防腐機能が無いために、長くても一年捨てるようにしてる。数か月使わなかっただけでも不安になるからそれより早く捨てるときも。
コロナがはじまってからは化粧品度もへり、大掛かりに捨てましたね…もっと少量で売って欲しい気持ち。+16
-0
-
91. 匿名 2024/01/01(月) 23:48:12
>>3
冗談やめろ+34
-0
-
92. 匿名 2024/01/01(月) 23:48:29
>>89
横
これ書いた人じゃないけど、
大腸菌てそこら中に蔓延してるらしい。
私もトイレだけのものかと思ってたけど。
人間が健康なときは免疫で耐えられて害が起こらないらしいけど、弱くなってるときは感染?するらしい。最近テレビかなんかでやってて知った+59
-1
-
93. 匿名 2024/01/01(月) 23:50:18
>>5
横だけど健康被害出ても原因の特定が難しいよね
食べ物とか顔の傷の可能性もあるかもって書いてる人もいるし
安物とか値段は関係あるのかも気になる
私は5年前とかの古いコスメで特に違和感ないけど、ブラシとかパフとかマメに洗ってることは関係あるのか分からない+42
-1
-
94. 匿名 2024/01/01(月) 23:50:53
>>30
ロクシタンのシャンプーだったかボディクリームだったかのサンプルを大事にとってあって、使おうとしたら開封した瞬間に油が腐ったような異様な匂いがして、びっくりして捨てたことある。
一回使い捨ての破って開封するタイプのは悪くならないと思ってた…+55
-4
-
95. 匿名 2024/01/01(月) 23:55:26
>>81
私、ブラシの他人との共有が不潔で嫌いだから、美容院で顔についた毛をブラシで取ってくれるときにブラシ使われるんだけど、私それやらないでくださいって言ってる。美容師さん神経質だな〜っ顔されたけど、普通に不潔で嫌過ぎる。
そこの美容院色々不潔っぽいんだよ。
ケープが雑巾みたいな生乾き雑菌の匂いするときあるし。
もう行ってないとこだけど。
全体的に美容院いったあとは来ていった服脱いでシャワー浴びたい。+65
-6
-
96. 匿名 2024/01/01(月) 23:55:31
目の周りに使うものは特に古くなったのは使っちゃダメなのはわかるけど、アイシャドウなんて絶対使いきれないし一年にこれ一つって訳にはいかないよね
なんだかんだで数種類は持っていたいしそんなにたっぷり塗らないから三年でも使いきれないわ+54
-0
-
97. 匿名 2024/01/01(月) 23:56:58
>>18
YouTuberとかめっちゃコスメを買う人いるけど、私みたいにたまにアイシャドウ買う人でもひとつ買うとなかなか使いきれないのに
仕事とはいえどうしてあんなに買うんだ?!と思ってる。+69
-2
-
98. 匿名 2024/01/01(月) 23:57:12
>>68
使いきれなくてもそこまでしか品質保証しないと言うことでは?
それ以降は自己責任+19
-0
-
99. 匿名 2024/01/01(月) 23:59:21
さすがに10年経過したものを使うのは非常識な気がする。+20
-1
-
100. 匿名 2024/01/02(火) 00:00:13
>>97
あれって宣伝だよね?提供されてるんだと思ってる。
もしそうじゃなくても、収益で元取れるのでは?+42
-2
-
101. 匿名 2024/01/02(火) 00:01:38
>>1
7年前のCCクリームとパウダー残ってたから使ったら、毛穴に入り込んだみたいな見た目にみるみるなってカルメ焼きみたいに皮膚がボコって膨らんで硬くなった事あるよ
おかしいと思ったから洗い落としても洗い落とせた感覚があまりなく、5日くらい顔の皮膚がカチカチに硬かった
古いのは使っちゃダメだと思い知った+56
-1
-
102. 匿名 2024/01/02(火) 00:01:48
>>92
だってトイレ出て手を洗わない人いるし、自分は小でもボタンやドアノブは大した人が触ってるのに
その手で触ったお金に大腸菌付いてるのに、机に置いたりして、そりゃそこここにいるよね+52
-1
-
103. 匿名 2024/01/02(火) 00:02:55
>>98
むしろ使い切れる人のほうがすごいよね。
私は一年くらいたったものには見えなくてもカビが繁殖してると思うから捨てる。肌のほうが大事。+28
-0
-
104. 匿名 2024/01/02(火) 00:04:56
古いの使っているけど影響出たことない
日焼け止めだけはその年に使い切るし、基礎化粧品はそこそこで使い終わってるけど
粉ものは全部コロナ前からのだ
在宅勤務になってぜんぜん減らない
表面アルコールで拭ったり、ブラシメンテとかはしてるけれど
まだ未開封もあるわ+21
-4
-
105. 匿名 2024/01/02(火) 00:09:50
>>1
それこそ自分10年前のアイシャドウ(キャンメイク)のやつたまに今でも使ってるけど何ともない
何か起こる前に捨てた方がいいのかな+33
-3
-
106. 匿名 2024/01/02(火) 00:16:06
>>79
ボディクリームは毎日全身に塗るからニベアくらいのボトルなら2〜3ヶ月でなくなる。40歳乾燥肌だけど、毎日ケアしていると肌ツルツルピカピカになるよ。+10
-7
-
107. 匿名 2024/01/02(火) 00:18:59
鏡がついてるコスメの捨て方がわからないまま数十年経つ+12
-1
-
108. 匿名 2024/01/02(火) 00:20:04
>>43
先月まぶたのまつ毛の生え際の皮剥いてたのに最近出たばかりのアイシャドウ使って片目の上まぶただけぼっこり腫れた…
もう1か月近いのでほぼ治りかけてはいるけど新しくても傷あったら無理よ…って体感…+25
-1
-
109. 匿名 2024/01/02(火) 00:21:24
>>97
環境汚染の元にもなってると思う…+17
-2
-
110. 匿名 2024/01/02(火) 00:22:47
>>97コスメ比較して早く動画にアップするのが仕事だしね・・・コスメ断捨離アップしてる美容YouTuberの動画いくつか見たけど適当にコスメ収納して臭くなってるのは捨てるとか言ってたわ+31
-1
-
111. 匿名 2024/01/02(火) 00:24:49
>>110適当にコスメ収納してるなと思ったのは自分の感想です。臭くなってるのは捨てますとか言ってて提供品多いし仕事だから仕方ないんだろうけど、コスメ好きとは?って思ってしまった+31
-1
-
112. 匿名 2024/01/02(火) 00:31:33
前に化粧品の製造の仕事をしてる人のブログかなんかで読んだんだけど、製造後3年以内に変質するもの以外は製造年月日を明記する必要がないけど、逆に3年経ってすぐ変質するものを製造するほうが難しいって。製造年月日がないものは未開封なら3年以上、もっと持つと思ってる。さすがに10年となると不安だから、見た目と匂いに変化がないか確認するとは思うけど。+40
-1
-
113. 匿名 2024/01/02(火) 00:34:24
ビューラー借りて使ってたら目が腫れた事ある。
人のビューラーは使わない方がいい。+21
-2
-
114. 匿名 2024/01/02(火) 00:35:48
>>20
ストレスを抱えているのですね。どうか、あなたが、優しい気持ちになりますように。+21
-1
-
115. 匿名 2024/01/02(火) 00:44:05
>>1
もろ直接肌に付ける基礎化粧品や下地ならまだしも、一番外側に付けるチークやシャドーでそんなになる?
15年以上前に貰った大手国産メーカーの試供用シャドー何セットかが家でだけだと消費しきれなくてまだ残ってるけどトラブルに一切なった事ないな
ちなみにチップやブラシはまめに変えたり洗浄してる+13
-5
-
116. 匿名 2024/01/02(火) 00:46:31
>>22
わーwこれ持ってたw
平成ギャルってかんじw+80
-2
-
117. 匿名 2024/01/02(火) 00:47:40
>>113
今は改善されてるかもだけど昔からメイクさんのマスカラで結膜炎やものもらいうつったりするっていうものね
目薬の貸し借りもしない方がいいよ+22
-0
-
118. 匿名 2024/01/02(火) 00:53:43
>>22
私がはじめて使ったアイシャドウじゃん、20年前に。+53
-1
-
119. 匿名 2024/01/02(火) 00:55:25
ビューラーは20年位使ってるかもw
それくらいでコスメはまだたっぷりあってもマメに処分してる+0
-1
-
120. 匿名 2024/01/02(火) 01:08:05
>>25
粉物は平気らしいね。リキッド系はアウト+33
-3
-
121. 匿名 2024/01/02(火) 01:09:16
プチプラコスメをいろいろ買ってしまうのでコスメボックスがごちゃごちゃになってる
すごい古い物は燃やせないごみで処分したけど化粧品の処分方法がいまいちわからない
忘れなければマスキングテープに使い始めた日を書いて貼ってる
SHISEIDOの高いリキッドファンデーション一時期気に入って使ってたけど、二~三年前とかに買った気がするから捨てたほうがいいよね…
アイシャドウも気を付けないと腫れることあるんだな+8
-1
-
122. 匿名 2024/01/02(火) 01:18:32
>>17
チークは肌が荒れるくらいだろうけど目は内側に影響出る可能性大きいから気をつけないとね+34
-0
-
123. 匿名 2024/01/02(火) 01:21:52
一度でも使ったら半年とかで捨てないといけないと思ってた+6
-2
-
124. 匿名 2024/01/02(火) 01:38:15
>>15
ファンデーションよりスポンジ?パフ?が臭いんじゃなくて?+10
-0
-
125. 匿名 2024/01/02(火) 01:51:02
使い切れないですね+4
-0
-
126. 匿名 2024/01/02(火) 02:00:16
>>28
ビューラーはゴムをとりかえたらいいんでないの+72
-0
-
127. 匿名 2024/01/02(火) 02:00:25
数年前廃番になったチークがどうしても欲しくてネットで探したら楽〇の某ショップにあったので注文しました
付けたら頬にブツブツが出来て跡が残ってしまいました+11
-1
-
128. 匿名 2024/01/02(火) 02:22:46
>>1
いや…10年前とかあり得ない。劣化とか考えないの?
なんで保管してるのかが分からん。
今どこでも化粧品やスキンケア用品揃うのにわざわざ危なそうな物使う理由がわからん。
+12
-3
-
129. 匿名 2024/01/02(火) 02:34:14
・水分油分が多く含まれるもの
・空気に触れやすい容器
・直接肌に触れるもの
・防腐剤なし
は品質劣化スピードが早いよね。
チップ型のもの(リップ、リキッドコンシーラーなど)や筆ペン型コンシーラーは早そう。アイグロウジェムも指突っ込むしなー。
ちゃんと管理してるのはマスカラとティントリップ系。
マステに開封年月日と廃棄予定日書いて貼ってる。+10
-0
-
130. 匿名 2024/01/02(火) 02:50:53
アイシャドウって無くならないよね+13
-0
-
131. 匿名 2024/01/02(火) 03:09:48
カラコン外さず4年着けてるけど平気
逆に外すとなんか保護が無くなった感じで眼球スースーして痛くなる
そろそろ買い換えるかな
ちなみに眼球に傷ついたらしく黒目が何ヶ所か白く濁ってて治らないと言われたわ+1
-29
-
132. 匿名 2024/01/02(火) 03:20:39
そんな古いの使うくらいなら百均買った方がマシ…+8
-2
-
133. 匿名 2024/01/02(火) 03:24:48
>>15多分パフとかコロッケ状態なんでしょうね、、、![古い化粧品を使って起きたトラブル…]()
+4
-11
-
134. 匿名 2024/01/02(火) 03:36:07
>>68
もったいないから気に入ってるものやデパコスは優先的に使うようにしてるよ。逆にあまり使ってないものやプチプラは処分しちゃった
ディオールのアイシャドウは3年4年はいける気がしてる。指で直接触れないように心がけてる+12
-0
-
135. 匿名 2024/01/02(火) 03:39:19
液状のものは気にしてる。マスカラ、アイライナー、ファンデーション、下地、グロスは特に。口紅も変な匂いがしたり新品の時とちょっと変化があったら処分してます
粉物でトラブルが起きたことないのですがさすがに10年前のものは持ってないなぁ
主さんはそれ処分してプチプラでいいから新品の買い直した方がいいかも+6
-0
-
136. 匿名 2024/01/02(火) 04:04:14
古いアイライナー使ったら睫毛の生え際がずっと痒くて二重も腫れた+5
-0
-
137. 匿名 2024/01/02(火) 04:25:02
>>14
使い始めてからの期限はまた別だからね+7
-1
-
138. 匿名 2024/01/02(火) 04:26:59
>>130
全部ミニサイズにして欲しい
パレット買うのもやめて同じものばかり使っても
使いきれなくて
それなりに時期来たら捨ててる+38
-0
-
139. 匿名 2024/01/02(火) 04:28:08
>>123
クリームシャドウとかだとそうだと思う+3
-0
-
140. 匿名 2024/01/02(火) 04:33:28
>>5
化粧品って何もない場合は恐ろしく持つよね
+21
-1
-
141. 匿名 2024/01/02(火) 04:38:26
>>10
でも化粧品って明らかに期限内に使い切れない量だよね
下地とか以外は
期限書いちゃったら、使い切れない量を売ってるのが問題視されそうだからやらない気がする
+60
-1
-
142. 匿名 2024/01/02(火) 04:42:43
>>19
書けないだろうね
なんか買ってすぐ変な油臭い匂いがした事ある
リキッドファンデーション
古いものが売れ残ったら廃棄とかやってたら儲からなくなるからやってくれないだろうね+32
-0
-
143. 匿名 2024/01/02(火) 04:53:49
>>137
開封後も期限書いてあるよー
大体12Mが多いかな
たまに6Mとか。+1
-1
-
144. 匿名 2024/01/02(火) 06:14:23
10年位ポイントメイクして無くて急にメイク欲出て来てとりあえず古いの使ってみた時は何事もなく使えた。ピエヌ、ディオール、シャネル、マックスファクターの商品、臭いも変色も無かったけど流石に捨てました。+7
-0
-
145. 匿名 2024/01/02(火) 06:23:00
ファンデ、毎日塗らないから100%ダメになる。クッションファンデは便利だけど菌が繁殖してそうで苦手。+13
-0
-
146. 匿名 2024/01/02(火) 06:45:14
>>5
あれ一生無くならないんじゃないかと思って3〜4年で怖くなって捨てた(笑)
その時点でも全然減ってなかった
チップやブラシの手入れをしてたら大丈夫そうな気はする+41
-1
-
147. 匿名 2024/01/02(火) 06:47:18
1年以上使ってないリップを久しぶりに使ってピリピリしてすぐ取って勢いよく捨てたことはあるな
基本荒れないんだけどたまに合わないのに遭遇して顔腫れたりするから2年使ってなかったら捨てる。+7
-0
-
148. 匿名 2024/01/02(火) 07:01:39
>>56
口や喉に違和感なくていきなり嘔吐になる人もいるみたい
私が海老アレルギー発症した時にそうなった+11
-0
-
149. 匿名 2024/01/02(火) 07:50:07
>>14
韓国コスメは期限より成分の方が心配+84
-8
-
150. 匿名 2024/01/02(火) 07:52:54
>>22
安室が紅白復帰した時瞼がキラキラしていてその後に発売された気がする。+32
-0
-
151. 匿名 2024/01/02(火) 08:20:48
>>22
これ持ってた
20年前だね
懐かしい+40
-2
-
152. 匿名 2024/01/02(火) 08:22:21
>>30
1年前の基礎化粧品のパウチのサンプル
明らかに香り飛んでたから捨てました
古いのは処分します+7
-0
-
153. 匿名 2024/01/02(火) 08:42:25
>>5
粘度のあるものは傷んだりあるけど、粉物とか10年前のコスメでも使えし、別にそれで荒れたことないな。+23
-4
-
154. 匿名 2024/01/02(火) 08:43:47
>>74
横だけど、何も書いてないもよは開封から3年
というルールだよ+3
-2
-
155. 匿名 2024/01/02(火) 08:49:07
>>14
アジアのは製造過程も信用ならないから、あった方が無難だよね。デパコスは気にしないかも。両方使う。マイナスだろうけど、あんまり過敏な意見は短期で買い替えさせたいコスメ業界の陰謀のような気がしてしまうかな。+25
-4
-
156. 匿名 2024/01/02(火) 08:50:41
>>25
そうそう+6
-0
-
157. 匿名 2024/01/02(火) 08:51:55
10年前のアイシャドウ、チーク使ってるけど今のところなんともない
デパコスです+9
-3
-
158. 匿名 2024/01/02(火) 08:52:49
>>48
教えてくれてありがとう!そういう意味なんだあれ。+3
-1
-
159. 匿名 2024/01/02(火) 08:54:25
>>1
悪いけど自業自得だよ
安物なのにいつかったかわからないなんて
私はシッカロールをパウダーがわりにして、顔があれて皮膚科に行った
これも自業自得+10
-5
-
160. 匿名 2024/01/02(火) 08:58:38
>>18
アイシャドウ全カラー購入してる人とか絶対余るよね?
本当どうしてるんだろう+17
-1
-
161. 匿名 2024/01/02(火) 09:04:07
>>110
悪くなってないのは、親戚友達に配ってるって言ってる人も結構いるよね。+12
-0
-
162. 匿名 2024/01/02(火) 09:05:57
恐くなって、メイク道具を確認しました
使わないのに、つい増えちゃうのよね+8
-0
-
163. 匿名 2024/01/02(火) 09:36:53
>>5
買い替えないって、どんだけケチなん?+5
-11
-
164. 匿名 2024/01/02(火) 09:37:02
>>11
アイシャドウはもう趣味って割り切ってる笑+23
-1
-
165. 匿名 2024/01/02(火) 09:53:09
ボビーブラウンのハイライト大きすぎて、10年前くらいのやつがちっとも減ってない。+10
-0
-
166. 匿名 2024/01/02(火) 10:09:23
>>1
古い口紅使って、唇の淵に水膨れが大量発生した!!
そういや、それ、変な油っぽい匂いしてたわ…😭+12
-1
-
167. 匿名 2024/01/02(火) 10:12:56
>>37
ハイライトが全く減らない。
捨てるのも勿体無いし…
今の所健康被害はないけどクレドのハイライト
奮発して買ったから捨てるのも惜しい…+10
-0
-
168. 匿名 2024/01/02(火) 10:23:27
>>95
それは1000円カットとかなのかな?
私の行ってるところだと、顔についた髪の毛はコットン渡されて自分で取るシステムです。
不潔な感じが嫌なのであれば、もう少し高いお店に行った方が…+5
-9
-
169. 匿名 2024/01/02(火) 10:34:41
1年以上経った化粧品は使わない方がいいよ+6
-2
-
170. 匿名 2024/01/02(火) 10:48:07
>>6
3年経つ前に油が劣化したにおいになる+7
-1
-
171. 匿名 2024/01/02(火) 11:04:09
>>30
そもそも渡された時点で古そうじゃない?
ドラストで働いてるけどメーカーからいつ貰ったかわからないサンプルいっぱいあるよ
デパコスはわかんないけどちゃんと管理してんのかな+14
-0
-
172. 匿名 2024/01/02(火) 11:09:12
>>8
横だけど
見えなくてもSNSもYouTubeも出来るよ?
iPadの音声読み上げ機能を使ったりして
盲目の人でも実際やってる人いるし+11
-2
-
173. 匿名 2024/01/02(火) 11:11:21
>>3
適当な事言わないほうがいいよ。風説の流布で訴えられるよ+14
-5
-
174. 匿名 2024/01/02(火) 11:19:47
>>14
あなたはずっと韓国コスメだけ使えば安心だね+11
-20
-
175. 匿名 2024/01/02(火) 11:19:48
>>77
カルミン(コチニール)アレルギーについて教えてくれた方、ありがとうございます!!
自分はなぜか青みピンク〜紫のアイシャドウだと高確率で瞼が焼いたモチのように膨れ上がって眼が充血するんだけど、
原因はどうやらカルミンもしくはマイカ(種類による)アレルギーだったみたい…
新品なのに結膜炎になったアイシャドウの成分見たら100%コレが入っていて、なぜピンク系パールやらアイカラーだと荒れるのか?長年の疑問から解放されました。
トピずれすみません。+55
-1
-
176. 匿名 2024/01/02(火) 11:45:39
>>54
半年でカビ!?
よっぽど保管の仕方が悪かったとしか…。+7
-0
-
177. 匿名 2024/01/02(火) 12:10:55
昨日5年位前に買った口紅つけたら少しピリピリしたので捨てたよ 腫れたりはしなかったから良かった
プチプラだしまだ店頭にあるからまた買おうかな+5
-0
-
178. 匿名 2024/01/02(火) 12:24:36
>>18
自分でも言ってるじゃん、“コレクション"だって。
コスメは、使って楽しむ、集めて見て楽しむの二種類の楽しみ方がある。
骨董品を集めたり、ナイキのスニーカーを集める人と同じ。
見て飾って楽しむんだよ。+29
-1
-
179. 匿名 2024/01/02(火) 12:27:26
>>14
マイナス多いし韓国コスメのコメントすると叩くのがガルちゃん。厳しいね。+17
-6
-
180. 匿名 2024/01/02(火) 12:48:01
>>19
パッケージが日焼けしてる(LED電球でも焼けるんだっけ?)のは避けてる+11
-0
-
181. 匿名 2024/01/02(火) 13:27:11
化粧品じゃないけど、10年位前の虫除けスプレーで蕁麻疹と熱が出た。+4
-0
-
182. 匿名 2024/01/02(火) 13:44:43
>>7
30年前のアザレのファンデつけても
平気だったよ+2
-1
-
183. 匿名 2024/01/02(火) 14:00:23
>>22
可愛い。これじゃないけど私が初めて買ったアイシャドウはケイトのだった。
マイカラーシャドウっていうスティック型の。+9
-0
-
184. 匿名 2024/01/02(火) 14:07:49
>>16
それ思いました。忘年会で食べたもの一応思い出して覚えていた方がいいかも。
あと古い化粧品は捨てよう+46
-0
-
185. 匿名 2024/01/02(火) 14:09:22
>>177
同じ色売ってるなら買いかえたいね!コロナ禍前に購入したコスメの処遇をどうしようか迷ってまだ捨てられない人たくさんいる気がする+3
-1
-
186. 匿名 2024/01/02(火) 14:12:15
>>5
怖いからアイシャドウの古いのあとで捨てます!+12
-0
-
187. 匿名 2024/01/02(火) 14:13:35
>>22
懐かしい。買ってつかってた。+11
-0
-
188. 匿名 2024/01/02(火) 14:34:27
去年の年末、化粧品の断捨離してグロス系のやつは全部捨てた。
口紅系は表面だけ拭けば使えるかな?とか、アイシャドウは粉物だから使えるかな?って残しておいたけど、やっぱり使わないほうがいいのかな。
ちなみに5年くらいはたってるやつ。+5
-0
-
189. 匿名 2024/01/02(火) 14:48:56
>>18
プロのメイクさんとかも。あの数どうメンテナンスしてんのか謎。+6
-0
-
190. 匿名 2024/01/02(火) 14:58:57
PayPayフリマで雪肌精のシートマスク6枚1400円で買ったら
中身が茶ばんでて変な臭いがして捨てた!
安物買いの銭失いだった!!+10
-1
-
191. 匿名 2024/01/02(火) 15:02:01
>>185デパコスや廃盤になったコスメはなかなか捨てにくいよね
+10
-0
-
192. 匿名 2024/01/02(火) 15:05:30
初めて使ってみる真新しい商品で合わなくて腫れ上がったりすることはあるけど、古かったから異常が出たってことはないな。私もよく考えたらすごい年数経ってる?ってのあるけど。見た目にヤバくなってたり、異臭がしたりのやつはさすがに捨てるし。そうでないもので古いやつは特に何ともない。本当はいけないんだろうけど笑
私はメインのメイク用品は洗顔後しか使わないようにしてる。時間が経ってからの顔って、ホコリ・自分の脂とかでかなり汚いって思ってるから。化粧直し用と完全に分けてる。化粧直し用は減りが早いから期限が気になるような使い方になることはない。+12
-1
-
193. 匿名 2024/01/02(火) 15:09:06
>>1
アレルギー体質で薬疹もでたりするけど、化粧品はないな。いま15年前お気に入りだったアイシャドウとチークを掘り起こして使ってるけど問題なし、ただ体質によるのと時の運なのでおすすめしない真似しないほうが良い、すべて自己責任。+12
-0
-
194. 匿名 2024/01/02(火) 15:38:46
>>1
化粧品好きで集めていて10年20年前のもまるけど全く問題ないよ。敏感肌で美顔器でもブツブツになったりする肌だけど大丈夫。
ブラシが不潔だったとかはない?
ブラシだけは変えてるよ。+4
-4
-
195. 匿名 2024/01/02(火) 15:49:42
>>106
きんもきんも+0
-1
-
196. 匿名 2024/01/02(火) 16:31:13
>>36
パウチって気温や体温が伝わりやすいから使用期限は普通の商品より短いって思ったほうがいい。未開封だからって油断してると成分が分離してたりする場合ある+11
-0
-
197. 匿名 2024/01/02(火) 16:44:52
使用期限や製造日を記載してる化粧品あるよ
私の勤めてる会社もそこの化粧品メーカーの真似して、一時期は使用期限とか製造月の記載してた。
買ってから使用期限があるならいらないって返品が増え、もっと新しい製造のが欲しいと交換希望が増えた。(うちは買ってから2週間以内なら返品交換できる)
導入してから数年で製造年や使用期限の記載をやめた。そもそも法律で化粧品の使用期間書くことは義務じゃないし、企業にとっては不利益しかなかった。
防腐剤入れてるから未開封3年は品質変わらない。防腐剤入れてないオーガニックや無添加化粧品は使用期限かいてある。
開封後も清潔な筆にとったり、吐出口触らないとか清潔に気をつければ問題ない。
指でアイシャドウ取る人とか、洗ったことないブラシやチップを使う人はまじで1年経ったやつは捨てたほうがいい+8
-0
-
198. 匿名 2024/01/02(火) 17:03:17
10年前に買った資生堂マキアージュのグロスとファンデーション&下地をいまだに使ってますが唇も肌も荒れたことが一度もありません。
あんまり化粧してでかけることが少ないから化粧が減るのが遅いのと生来の貧乏性なのもあります。+7
-0
-
199. 匿名 2024/01/02(火) 17:05:47
気に入ってたけど廃盤になっちゃた
パウダーをチビチビ使ってしまってる
在宅で気合の入ったメイクを
あまりしないから無くならないんだよね+3
-0
-
200. 匿名 2024/01/02(火) 17:15:51
>>133
使用済み洗って使ってるけど
毎回使い捨てなのみんな?+3
-0
-
201. 匿名 2024/01/02(火) 17:22:50
>>7
シャネルのチークめちゃくちゃ持つから普通に10年超えた。コスパ良すぎて私にとってはタダみたいなもんだ。+10
-0
-
202. 匿名 2024/01/02(火) 17:30:43
毎年福袋で大量の小袋のサンプルをもらって使い切れていないのでと
美容部員さんに言ったらサンプルは1年が消費期限です。
と教えてくれました。
+8
-0
-
203. 匿名 2024/01/02(火) 17:35:17
化粧品は買った日と開封日を外装に書いておきます。
いつ開封したのか忘れてしまってずるずる使い続けてしまうから。
化粧品だけでなく調味料、コンタクト液などもね。
開封後はお早めにってあるけどどんぐらいの早めなんだろう
+13
-1
-
204. 匿名 2024/01/02(火) 17:55:05
>>14
韓国コスメって書くだけでマイナスつくの過剰反応だよね。
今は厳選して国産を使ってるけど、コスメ好きで色々買ってた時は韓国コスメもあってコスメ断捨離する時使用期限書いてあったから迷わず捨てられて助かった。日本もそうして欲しいなと思うよ。+28
-3
-
205. 匿名 2024/01/02(火) 18:33:05
>>14
中国と台湾も書いてあるよ+0
-0
-
206. 匿名 2024/01/02(火) 19:12:22
>>4
水分や油分が入ってないパウダー系は5年くらい使えると聞いたけど本当かな+2
-1
-
207. 匿名 2024/01/02(火) 19:12:38
>>195
こんばんは、ガサガサさん!+0
-0
-
208. 匿名 2024/01/02(火) 19:13:22
>>200私も洗って使ってるよ。肌弱いしニキビもできやすいからなるべくせいけつにしたくて、常に5枚くらい洗い立てを用意して、毎回か最低でも2回に1回は替えてます。
洗ってボソボソになったら迷わず捨てます。
自分の肌が1番大事!
+14
-0
-
209. 匿名 2024/01/02(火) 19:24:22
>>206
ルースパウダーとかレフィル挟まずにパフとか収納してたら良くない。
ティッシュにパラパラ出して、パフに十分に含ませて使ってる。
そのパフは次の日は裏にして使う。(大体が裏表同じ素材だから)
そして洗うってことを徹底してる。2回(裏表一回づつ)使ったら洗う。
+4
-0
-
210. 匿名 2024/01/02(火) 19:25:17
>>209
ごめんなさい。
❌レフィル️⭕️フィルム+4
-0
-
211. 匿名 2024/01/02(火) 19:28:00
>>188
口紅5年でもなんともないのもあるから手の甲に塗って様子みたり匂い嗅いで判断したらいいかも。私なら処分するかもしれない
グロス系とマスカラ、アイライナー、リキッドファンデなどは消費期限短いからこまめに交換がいいかも。アイシャドウやフェイスパウダー、チークは大事に使って4、5年経ってるのもあるよ+6
-0
-
212. 匿名 2024/01/02(火) 20:01:18
10年前に買ったクレドのチーク、使ってもなんともない
使用感も変わらない
たまにしか使わないから無くならない+6
-0
-
213. 匿名 2024/01/02(火) 20:04:42
>>1
20年前のも問題なかった+3
-0
-
214. 匿名 2024/01/02(火) 20:09:38
>>70
え?45歳じゃなくて?
私も今年35だけど高校の頃はこれじゃなかったと思う+10
-1
-
215. 匿名 2024/01/02(火) 20:27:54
>>14
韓国コスメだからってマイナス食らってるの可哀想
私も韓国コスメ買ったときに、開封日を書くシールも入ってて親切!!って思ったな+10
-4
-
216. 匿名 2024/01/02(火) 20:44:40
>>25
コンタクトは男も使うけど、化粧品は基本女だからなぁ
+0
-0
-
217. 匿名 2024/01/02(火) 20:51:24
>>22
中1の時初めてかった化粧品+6
-0
-
218. 匿名 2024/01/02(火) 21:06:46
>>22
母(40代後半)が待ってた!!こっそりポーチから出してこれでお化粧の真似したの覚えてる〜+8
-0
-
219. 匿名 2024/01/02(火) 21:07:56
>>4
まだ使えるのに、新品を買ってもらうために使用期限書いてるのかなと思うちゃうかも+5
-0
-
220. 匿名 2024/01/02(火) 21:12:29
もう廃盤しちゃったけどメイベリンのbbクリーム買って開封前で1年放置したら中身が分離しちゃってクリームとオリーブオイルみたいになってた事がある…
怖くてすぐに捨てた!+12
-0
-
221. 匿名 2024/01/02(火) 21:24:05
>>1
メイクさんでチークやアイシャドウ、粉系ですね、それはちゃんと保管しながら使用している前提でしょうが、10年くらい大丈夫と言ってるの見たことありますよ!+0
-3
-
222. 匿名 2024/01/02(火) 21:46:58
古いというか化粧品売り場の試供品のクリーム手に少しぬって家に帰ってしばらくしたら赤い発疹がいっぱいできた。みんな汚い手ですくったりしてなんかの菌がクリームの中で繁殖していたのかな。+6
-0
-
223. 匿名 2024/01/02(火) 21:49:32
このトピを見て、コロナ禍でマスク生活になる直前に買っちゃって全然使わなかったローラメルシエのクッションファンデの存在を思い出した
久々に蓋を開けてみたらなんかアカン匂いが。化粧品に限らずだけど、良い気分で買ったものを捨てるのは悲しいね+10
-1
-
224. 匿名 2024/01/02(火) 21:52:18
>>117
フォトウェディングでメイクして貰う時、アイラインとマスカラは持参するよう言われた+3
-1
-
225. 匿名 2024/01/02(火) 21:55:44
6年前のシャネルとルナソルのアイシャドウつけたら
目がかゆくてかゆくて瞼腫れたし充血した
ほとんど使ってなくて勿体無いとずっと捨てられなかったけど痛みのおかげで迷いなくゴミ箱へ+10
-0
-
226. 匿名 2024/01/02(火) 22:09:29
美的の付録だったスックの諭吉ファンデ。3年ぶりに使ったら、ニキビ大量発生した。+4
-0
-
227. 匿名 2024/01/02(火) 23:08:32
>>17
アイシャドウじゃなくてマスカラだったような?
リキッド状というか、水分の多い化粧品って特に菌が繁殖しやすいから危険なんだよね+7
-0
-
228. 匿名 2024/01/02(火) 23:15:13
>>28
ゴムは使用有無や使用頻度関係なく劣化するからね。+5
-0
-
229. 匿名 2024/01/02(火) 23:22:39
30年前のアイシャドウつけて、今のところトラブルなし+3
-2
-
230. 匿名 2024/01/03(水) 00:47:17
もう廃盤しちゃったけどメイベリンのbbクリーム買って開封前で1年放置したら中身が分離しちゃってクリームとオリーブオイルみたいになってた事がある…
怖くてすぐに捨てた!+0
-0
-
231. 匿名 2024/01/03(水) 01:27:10
>>214
88年生まれの35歳ですよ笑
調べたらこのパケ2002年発売って書いてあったから私が中2の時に発売されてるし高校生の時もこれだったと思います+5
-0
-
232. 匿名 2024/01/03(水) 07:13:29
>>227
うん、マスカラなら私も知ってる
私はあまり使用期限気にしないけど、さすがに20年前のマスカラは使わないかな
![【海外発!Breaking News】20年前のマスカラを使った女性 「3年以内に失明」宣告受ける(豪) - ライブドアニュース]() 【海外発!Breaking News】20年前のマスカラを使った女性 「3年以内に失明」宣告受ける(豪) - ライブドアニュースnews.livedoor.com
【海外発!Breaking News】20年前のマスカラを使った女性 「3年以内に失明」宣告受ける(豪) - ライブドアニュースnews.livedoor.comオーストラリアに住む女性が20年前のマスカラを塗っておしゃれをした。痛みに襲われ受診すると、3年以内に完全に失明すると宣告されたという。とっくに使用期限が切れていたマスカラが原因で感染症を起こしていたそう
+5
-0
-
233. 匿名 2024/01/03(水) 08:16:47
>>70
99年発売って見たけど……
36だけど、中1.2とかだったはず。
プチセブンでめっちゃ見てたから覚えてる。+6
-0
-
234. 匿名 2024/01/03(水) 10:50:21
>>6
人からもらって使いきれてないハンドクリームいっぱいあるけどもらってから3年は経ってるわ😨+7
-0
-
235. 匿名 2024/01/03(水) 21:29:04
>>76
新品じゃなくて?+0
-0
コメントを投稿する
トピック投稿後31日を過ぎると、コメント投稿ができなくなります。削除すべき不適切なコメントとして通報しますか?
いいえ
通報する